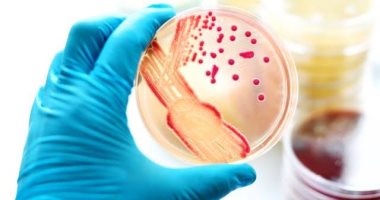

"تمكن العلماء من تسجيل الموسيقى التصويرية للبكتيريا من خلال تعزيز الظروف المناسبة لـ""حفلة"" الكائنات الحية الدقيقة، ووصف الفريق الصوت الناتج عن هذه التجربة في ورقة بحثية نُشرت في مجلة Nature Nanotechnology، حيث وضع العلماء هذه الكائنات وحيدة الخلية على مادة تسمى الجرافين، ثم جلسوا وانتظروا ليروا ما سيحدث.
ووفقا لما ذكره موقع ""RT""، يُعد الجرافين نوعا مختلفا فريدا من الكربون يُشار إليه أحيانا على أنه ""مادة عجيبة""، لأنه حساس للغاية للتحفيز مع سماكة ذرة واحدة فقط.
وأجرى الفريق تجاربهم الأولى على بكتيريا الإشريكية القولونية (Escherichia coli). وقال سيس ديكر، الباحث في جامعة دلفت للتكنولوجيا في هولندا والمؤلف المشارك للدراسة، في بيان: ""ما رأيناه كان مذهلا. عندما تلتصق بكتيريا واحدة بسطح أسطوانة الجرافين ، فإنها تولد اهتزازات عشوائية بسعة منخفضة تصل إلى بضعة نانومترات يمكننا اكتشافها. وسماع صوت بكتيريا واحدة"".
وفي الواقع، يبدو الصوت إلى حد كبير مثل نفق الرياح. وهذا صوت واحد من أصغر الكائنات الحية في الكون. وبشكل أكثر تحديدا، ما تسمعه هو صوت ذيول البكتيريا، أو الأسواط، التي تتفاعل مع أسطوانة الغرافين وتنتج حركات ذهابا وإيابا تسمى التذبذبات.
وتولد مثل هذه التذبذبات اهتزازات على سطح المادة، وقام العلماء لاحقا بتحويل كل ذلك إلى ضوضاء يمكنك سماعها.
وقال فاربود ألياني، الباحث في جامعة دلفت للتكنولوجيا، وزملاؤه: ""لفهم مدى ضآلة هذه الضربات السوطية على الغرافين، يجدر بنا أن نقول إنها أصغر بعشرة مليارات مرة على الأقل من لكمة الملاكم عند الوصول إلى كيس الرمل"". وتابع: ""ومع ذلك، يمكن تحويل هذه النغمات ذات النطاق النانوي إلى موسيقى تصويرية والاستماع إليها، وكم هذا رائع"".
ولكن بعيدا عن الذهول المطلق لهذا الاكتشاف، يمكن أن يكون لاكتشاف الفريق أيضا تطبيق طبي مهم، حيث قد يساعدنا الاستماع إلى أصوات البكتيريا على فهم فعالية المضادات الحيوية.
وخلال التجارب، رأى فريق الدراسة بوضوح أنه إذا كانت البكتيريا مقاومة للمضادات الحيوية، فإن دقاتها ستستمر. وإذا كانت البكتيريا تستجيب للدواء، تتباطأ الأغنية وتتباطأ حتى تختفي تماما.
وقال بيتر ستينكين، الباحث في جامعة ديلفت للتكنولوجيا والمؤلف المشارك آخر في الدراسة: ""ستكون هذه أداة لا تقدر بثمن في مكافحة مقاومة المضادات الحيوية، وهو تهديد متزايد باستمرار لصحة الإنسان في جميع أنحاء العالم"".
وأضاف ستينكن: ""بالنسبة للمستقبل، فإننا نهدف إلى تحسين منصة الحساسية للمضادات الحيوية من الغرافين أحادية الخلية والتحقق من صحتها مقابل مجموعة متنوعة من العينات المسببة للأمراض بحيث يمكن استخدامها في النهاية كأداة تشخيصية فعالة للكشف السريع عن مقاومة المضادات الحيوية في الممارسة السريرية"".
"
علماء يحصلون على تسجيل صوتى للبكتيريا قبل أن تُقتل
هل أعجبك هذا المقال؟
